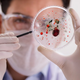
Zakaj nekateri virusi ostanejo v telesu za vedno

Ko prebolimo prehlad, gripo ali večino virusnih okužb, se telo postopoma vrne v normalno stanje. A obstaja posebna skupina virusov, ki se obnaša povsem drugače. Ne izginejo. Ne umrejo. Ne … · Vizita.si · 1h
herpesviridae imunski sistem virusna latenca latentni virusi preventiva virusnih okužb objavi tvitaj

V sodobnem tempu življenja, kjer se zdi, da je hitrost edina stalnica in nenehna zaposlenost statusni simbol, je beseda utrujenost postala trdno zasidran del našega vsakdana. Vsi smo kdaj utrujeni. … · Dnevnik · 15h
prepoznavanje simptomov stres izgorelost osebna preobrazba utrujenost herbert freudenberger okrevanje duševno zdravje delo in življenje christina maslach objavi tvitaj

Brigitte Bardot (1934-2025) je danes znana kot močno kontroverzna osebnost, ki je bila v domači Franciji večkrat pravnomočno obsojena za sovražni govor proti priseljencem zlasti muslimanske veroizpovedi. Težko je razumeti … · RTV Slovenija · 1d
roger vadim brigitte bardot in bog je ustvaril žensko tv namig objavi tvitaj

Krvni test lahko razkrije, ali se vaše telo stara hitreje od dejanskih let. Znanstveniki so odkrili 10 ključnih biomarkerjev biološke starosti. Poleg kronološke starosti, ki jo merimo v letih, obstaja … · Svet24 · 2d

Dolgotrajna utrujenost, razdražljivost in izguba volje niso vedno le posledica tempa. Preverite znake, ki lahko kažejo na prikrito obliko depresije. Pridejo obdobja, ko zjutraj vstanemo in naredimo vse, kar se … · Svet24 · 2d

Premier in predsednik Gibanja Svoboda Robert Golob je včeraj s predsedniki SD, Demokratov, Levice in Vesne ter Resnice nadaljeval pogovore o oblikovanju nove vlade. V NSi so znova zavrnili vabilo, … · Dnevnik · 3d
energetska politika geopolitične razmere robert golob politična negotovost koalicijska pogajanja zaščita gospodarstva boj proti korupciji prehranska varnost interventni ukrepi sestava vlade objavi tvitaj

V njegovih besedah ni jeze, temveč razočaranje nad časom, ki je očitno izgubil stik z lastno zgodovino. Čeprav ne smuča več, njegov um še vedno riše zavoje. Andrej Robič tudi … · Slovenske novice · 3d
elan smuči alpsko smučanje smučarska oprema ingemar stenmark objavi tvitaj